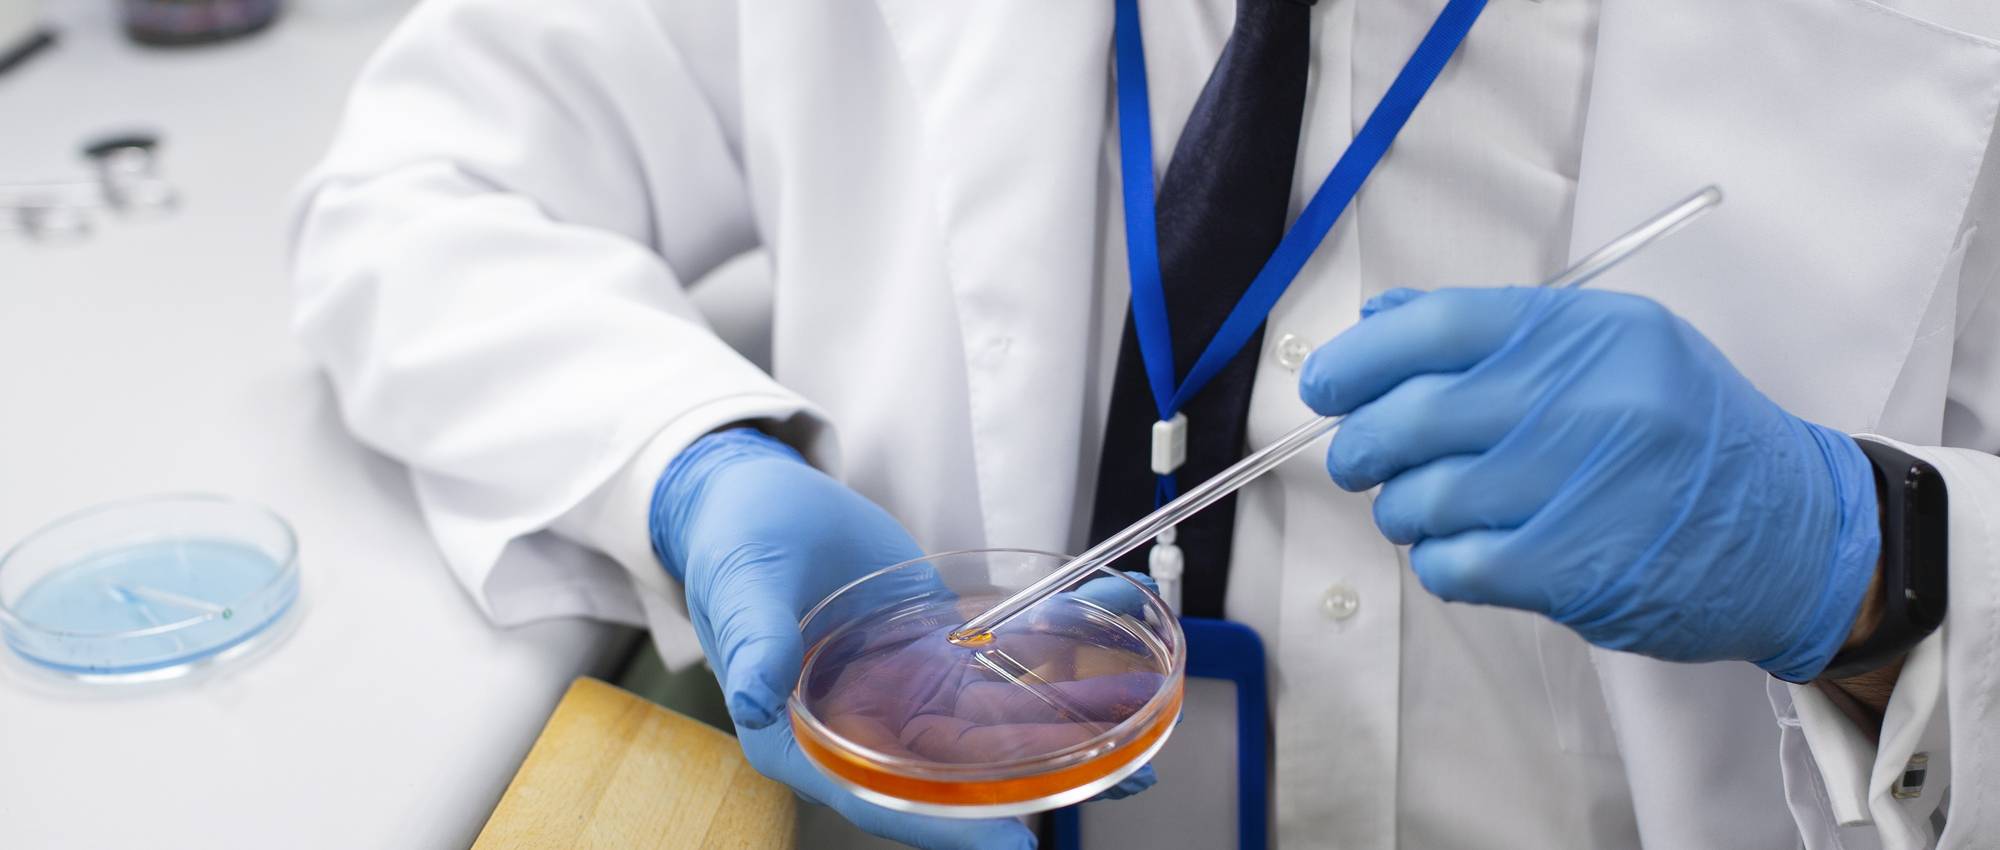

Dietetics & Nutrition
Our meals prove that hospital food can in fact be tantalizing..
Pathology is a branch of medical science that focuses on understanding the nature and causes of diseases by examining tissues, organs, bodily fluids, and cells. It is a critical discipline in medicine, as it provides the foundation for diagnosing diseases, guiding treatment, and conducting research to develop new therapies. Pathology can be divided into several specialized fields:
1. Histopathology
2. Cytopathology
3. Hematopathology
4. Clinical Pathology (Laboratory Medicine)
5. Forensic Pathology
6. Molecular Pathology
7. Neuropathology
8. Immunopathology